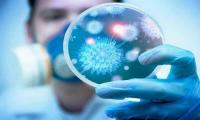

-
 متفرّقات
06 مارس 2020 (22:37)
متفرّقات
06 مارس 2020 (22:37)
هذه فوائد خل التفاح لمرضى السكري
-
 متفرّقات
06 مارس 2020 (22:27)
متفرّقات
06 مارس 2020 (22:27)
نجم شهير يطالب الشرطة بالقبض على والده بسبب معاملته السيئة
-
 متفرّقات
06 مارس 2020 (22:19)
متفرّقات
06 مارس 2020 (22:19)
الدورة الثانية لجائزة أورنج للكتاب في القارة الافريقية: الإعلان عن القائمة النهائية للكتب الستّة المختارة لسنة 2020
-
 متفرّقات
06 مارس 2020 (22:16)
متفرّقات
06 مارس 2020 (22:16)
فلسطيني يتحدث عن رحلته مع كورونا بالصين
-
 متفرّقات
06 مارس 2020 (22:12)
متفرّقات
06 مارس 2020 (22:12)
الصحة العالمية توضح فرضية إختفاء كورونا في الصيف
-
 متفرّقات
06 مارس 2020 (21:56)
متفرّقات
06 مارس 2020 (21:56)
في عمر 101 عاما : تعافى من فيروس كورونا خلال أسبوع واحد
-
 متفرّقات
05 مارس 2020 (21:49)
متفرّقات
05 مارس 2020 (21:49)
منظمة بريطانية تؤكد مقتل طالب سوري بنيران الحرس اليوناني
-
 متفرّقات
05 مارس 2020 (21:45)
متفرّقات
05 مارس 2020 (21:45)
نانسي عجرم مفاجأة مسلسلات رمضان 2020..
-
 متفرّقات
05 مارس 2020 (21:36)
متفرّقات
05 مارس 2020 (21:36)
آخر الارقام والاحصائيات حول الاصابات بالكورونا في ارجاء العالم
-
متفرّقات
05 مارس 2020 (21:24)
متفرّقات
05 مارس 2020 (21:24)
ليس وحدها الكورونا .. هناك 7 أمراض تهدد العالم أثنين منهم من الصين










